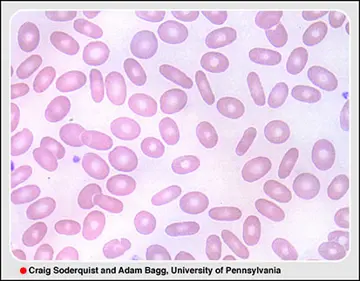

شماره ۱۰۰۷
هماتولوژی - صفحه 19
شماره ۱۰۰۶
شماره ۱۰۰۵
شماره ۱۰۰۴
تشخیص alveolar rhabdomyosarcoma نزد جوان31ساله گرفتار ضایعهی سینوس ماگزیلر طرف چپ با متاستاز Lymphonodular درماه مارس2012 محرز گردید.
شماره ۱۰۰۳
مرد چهلسالهیی بهعلت ضعف کاهشوزن و تودهیی در ناحیهی کشالهیران بهمدت 14مـاه دیدهشد.
شماره ۱۰۰۲
مرد 66 سالهی دیابتیک به علت تنگی نفس، استفراغ، تب دربیمارستان دیده شد
شماره ۱۰۰۱
ما روش(positron emission tomography+computed tomography(PET-CT را درمورد لنفوم DLBCL) Diffuse Large B-cell) بررسی کردیم تا ببینیم گرفتاری مغز استخوان دراین بیماران چه ارزشی دارد و آیا دقیقبودن آن جانشین بیوپسی مغزاستخوان خواهد شد؟
شماره ۱۰۰۰
برپایهی (Cancer and Leukemia Group ß (CALGß درمان استاندارد برای induction عبارتاست از 4دوره دوز بالای ARA-C 3gr بهازای مترمربع سطح بدن هر12ساعت روزهای ۳،۱و5 بهجای 100تا400 میلیگرم روزانه برای 7روز یا 5روز ماهی یکبار به عنوان درمان نگهدارنده.
شماره ۹۹۸
ATRA.Idarublcin. Arsenic for APL از زمانیکه ATRA) all-trans-retinoid acid) کشف شده کمک بسیار زیادی به درمان لوسمی پرومیلوسیتیـک کرده است به طوری که امــروز پیــوند مغز استخوان در این بیماری محلی ندارد.
شماره ۹۹۷
خانم 76ساله با لنفوم diffuse large B-cell درمرحلهی3ß با گرفتاری عقدههای لنفاوی retroperitoneal و یکطرف گردن و ناحیهی فوق ترقوه دیده شد.